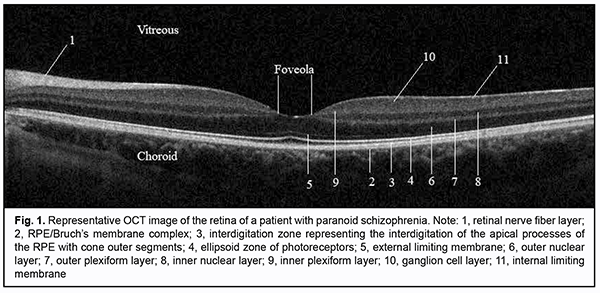

J.ophthalmol.(Ukraine).2020;4:38-44.
|
http://doi.org/10.31288/oftalmolzh202043844 Received: 24 April 2020; Published on-line: 27 August 2020 A structural and functional study of the retina in patients with schizophrenia K.E. Kozub1,2,Iu.E. Shelepin1,A.N. Chomskii3,E.A. Sharybin3, E.A. Ivanova4 1 Pavlov Institute for Physiology, Russian Academy of Sciences; St. Petersburg (Russia) 2 Modern Medical Technologies Clinic; St. Petersburg (Russia) 3 Bekhterev Institute of Human Brain, Russian Academy of Sciences; St. Petersburg (Russia) 4 Kashchenko Hospital; St. Petersburg (Russia) E-mail: kulikopp@mail.ru TO CITE THIS ARTICLE: Kozub KE, Shelepin IuE, Chomskii AN, Sharybin EA, Shabanova EA. A structural and functional study of the retina in patients with schizophrenia. J.ophthalmol.(Ukraine).2020;4:38-44. http://doi.org/10.31288/oftalmolzh202043844 Purpose: To examine the relationship between retinal structural parameters and visual perception function in patients with schizophrenia. Material and Methods: Twenty-four subjects (48 eyes) were included in the study. Group 1 (the schizophrenia group) comprised 11 patients with paranoid schizophrenia and one with schizotypical personality disorder, and Group 2 (the control group) comprised 12 mentally healthy subjects. Group 1 was subdivided into Subgroup A (disease duration of > 5 years) Subgroup B (disease duration of < 5 years). Subjects underwent a routine eye examination, assessment of contrast sensitivity threshold using Ergotest 3.0 software, and optical coherence tomography (OCT) of the retina using a Topcon 3D OCT 2000 apparatus in 3D Macula, Radial Macula and 3D Disc modes. Results: Compared to the control group, the patients with schizophrenia exhibited significantly (p < 0.05) lower contrast sensitivity threshold values at high spatial frequencies. The contrast sensitivity threshold at high spatial frequencies was negatively correlated with disease duration (p=0.046, r=-0.585). OCT-based macular parameters and the diameter of the foveola in these patients tended to increase compared with controls, but only differences in the macular volume (p = 0.035), superior inner retinal thickness (p = 0.022) and nasal inner retinal thickness (p = 0.003) for both eyes were significant. Conclusion: Our findings in patients with schizophrenia confirm previously reported evidence of dysfunction of the parvocellular visual channels in the early disease stages. In addition, they confirm the hypothesis that there is an association of an acute psychotic episode with neuroinflammation and subclinical retinal edema in the macula. Keywords: schizophrenia, optical coherence tomography, macular volume, retinal contrast sensitivity
Introduction The changes in the visual system in schizophrenia were noted by Kraepelin and Bleuler more than a hundred years ago [1]. Shamshinova [2] and Goldovskaia [3] systematically studied basic visual functions and effects of psychotropic drugs on these functions in patients with schizophrenia. Psychophysical and electrophysiological studies have demonstrated evidence of impaired visual perception levels in each of the hierarchical levels of the visual system, from the retina to the anterior areas of the visual cortex. This is manifested by the altered balance between magnocellular (M pathway) and parvocellular visual channels (P pathway) which in turn is expressed by changes in retinal contrast sensitivity and visual evoked potentials [4,5]. Given that central vision function is performed mostly by small receptive fields in the macular region which form parvocellular visual channels, obtaining information on the structure of the region in patients with schizophrenia may contribute to establishing the structural and functional relationship in the macula of these patients. Optical coherence tomography (OCT) enables studying the ultrastructure of the retina and optic disc in vivo (Fig. 1) at the histological level. OCT studies in patients with Alzheimer's disease [6], multiple sclerosis [7-9], and senile cerebral atrophy [10] have demonstrated evidence of thinning of the peripapillary retinal nerve fiber layer (RNFL) that consists mostly of ganglia axons. In addition, an OCT study by Tiganov et al [11] reported on thinning of the macular ganglion cell complex in Alzheimer's disease. Moreover, RNFL thinning has been demonstrated in dopamine-associated disorders such as Parkinson’s [12]. An OCT study by Moiseenko [13] has established the relationship between the size of the foveola and resolution of the eye and the effects of this size both on early VEP latencies and cognitive processes in reading. It has been hypothesized that the larger the foveola, the more foveal receptive fields are activated, which consequently stimulates the parvocellular visual system that enables high-frequency data transfer. Therefore, OCT studies of the retinal structures involved in the formation of the magnocellular and parvocellular visual channels may be important in patients with schizophrenia. The purpose of the study was to examine the relationship between retinal structural parameters and visual perception function in patients with schizophrenia. Material and Methods Group 1 (the study group) comprised 11 patients with paranoid schizophrenia and one patient with schizotypical personality disorder, with a mean disease duration of 8.5±5.4 years. Of these, 10 were in-patients with acute disease, and two were in remission for more than a year. All patients of this group were administered antipsychotic medications. Exclusion criteria were (1) high myopia with secondary changes in the fundus, (2) any macular disorder, or (3) optic neuropathy. Group 2 (the control group) was composed of mentally normal individuals. The two groups were matched in age and gender. At baseline, subjects underwent a preliminary eye examination that included autorefractometry, pneumotonometry, IOL Master axial length measurements, visual acuity assessment using digital optotypes, and the Mollon-Reffin minimalist color vision test. Thereafter, they underwent assessment of retinal contrast sensitivity threshold using Ergotest 3.0 software with gradual increases in spatial frequency of presented Gabor lattice from 0.3 to 9.0 cycles per degree of visual angle and in contrast from 0 to 1. Then patients had biomicroscopy of the anterior and posterior eye, and ophthalmoscopy using a 78D lens. Finally, the fundus was examined using Topcon 3D OCT 2000 in 3D Macula [6.0 х 6.0 mm – 512 х 128], Radial Macula [6.0 mm – 102 х 12] and 3D Disc modes. The foveal diameter was calculated as the mean of manually measured distance between the margins of the inner plexiform layer for six scans (0-, 30-, 60-, 90-, 120-, and 150-degree scans) in Radial Macula mode. The following optic disc parameters were assessed: optic disc area (Disc Area), cup-to-disc (C/D) Area Ratio, neuroretinal rim area (Rim Area) and total RNFL thickness (RNFL Total). Statistical analyses were conducted using Microsoft Excel and IВM SPSS 24. Descriptive statistics was performed in the form of mean and standard deviation for interval variables. Mann-Whitney test was used for independent sample comparisons. Single-factor analysis of variance (ANOVA) was used to detect significant differences between the groups. The Pearson test was used for paired sample correlation analysis. The level of significance p ? 0.05 was assumed. Results Table 1 presents demographic and clinical characteristics of the groups.
Biomicroscopy found no changes in the optical media or retina. The IOP values were within the normal range. Based on testing with the Mollon-Reffin test, [14] most subjects were normal trichromats, and one patient in Group 1 had a reduced blue color perception (D1P1T2). The contrast sensitivity threshold at high spatial frequencies was significantly (p < 0.05) lower in the patient group as opposed to the control group. Table 2 presents contrast sensitivity thresholds for both groups.
The contrast sensitivity threshold at high spatial frequencies was negatively correlated with disease duration (p=0.046, r=-0.585) (Fig. 2).
OCT-based macular parameters and the diameter of the foveola tended to increase compared with controls, but only differences in the macular volume (p = 0.035), superior inner retinal thickness (p = 0.022) and nasal inner retinal thickness (p = 0.003) for both eyes were significant. All parameters excepting the diameter of the foveola and retinal foveal thickness were significantly increased in patients of Subgroup A (those with a disease duration longer than 5 years) compared to controls. However, there was no significant difference in any parameters in patients of Subgroup B (those with a disease duration shorter than 5 years) compared to controls (Tables 3 and 4).
It is of note, that, a patient with exacerbated hallucinosis and a practically continuous disease course (with no remission for 12 years) exhibited the greatest macular volume among patients of Group 1, with average retinal thickness and macular volume of 297.3 ?m and 8.40 mm3, respectively, for the right eye, and 299.3 ?m and 8.46 mm3, respectively, for the right eye. No correlation was found between the size of the foveola and the contrast sensitivity threshold for high (r=0.07), medium (r=0.153), and low spatial frequencies (r=0.168). The size of the foveola is associated with the axial length and may give indirect evidence of the density of foveal receptive fields (Fig. 3).
We found no significant differences in morphometric parameters of the optic disc or RNFL thickness between the two groups (Table 5).
Discussion Our finding of significantly increased contrast sensitivity threshold for high spatial frequencies in patients with schizophrenia confirms previously reported evidence of dysfunction of the parvocellular visual channels in the early disease stages [4]. Neuromediator theory of schizophrenia involves the idea of the possible existence of the dopaminergic system dysfunction and differences in the functional status of mesocortical and mesolimbical dopaminergic systems. This may be manifested ultrastructurally by the development of atrophic or compensatory changes in the neuronal structures such as the retina [15]. Recent OCT studies in patients with schizophrenia have demonstrated contradictory results. Many of these studies reported reduced RNFL thickness [16], sometimes in combination with reduced macular volume and reduced retinal macular thickness [17-19], in patients with schizophrenia. In addition, the incidence of these changes increases with disease duration, which may be associated with prolonged psychotropic drug therapy and secondary atrophy of dopaminergic retinal cells. It has been reported that certain antipsychotics can cause degenerative retinopathies with features similar to those of primary retinitis pigmentosa. Some underlined the role of the drug effects on the activity of the retinal enzymatic systems preventing phototoxic effects. Others hypothesized that neuroleptic induced blockade of retinal D2/D4 receptors is among the initial events of these drug-induced degenerative retinopathies [20]. A study by Silverstein and colleagues [21] found no difference in RNFL or macula thickness between patients with schizophrenia and controls, but the former demonstrated enlarged optic disc parameters such as Cup Volume and C/D Area Ratio in both eyes. Of note is that the above study presented no values for optic disc area (Disc Area). It is known that the Сup Area, Rim Area and their ratio directly depend on the optic disc area (Disc Area). In macrodiscs with a normal Rim Area, C/D Area Ratio may be symmetrically increased [22]. A recent OCT study of patients with schizophrenia [17] found that, compared with controls, non-recent illness episode (NRIE) patients, but not recent illness episode (RIE) patients had significantly reduced RNFL overall measures, superior RNFL, nasal RNFL, macular volume, and macular inner ring thickness. Therefore, our findings and those from other studies strongly suggest that patients with acute schizophrenia have an increased retinal macular thickness. Given that most patients in our schizophrenia group (10 of 12) had acute disease during the study, our findings may confirm the hypothesis that there is an association of an acute psychotic episode with neuroinflammation and subclinical retinal edema in the macula. This study was financially supported by the Russian State Academies of Sciences Fundamental Research Program for 2013–2020 (SP-14, Section 63), Pavlov Institute for Physiology of the Russian Academy of Sciences. The study protocol was approved by the Ethics Committee at the Bekhterev Institute of Human Brain, Russian Academy of Sciences, at the meeting held on September 19, 2019, and written informed consent was obtained from each participant.
References 1.Cohen J D, Servan-Schreiber D. Context, cortex, and dopamine: a connectionist approach to behavior and biology in schizophrenia. Psychol Rev.? 1992 Jan;99(1):45-77. 2.Shamshinova AM. [Changes in the visual system during treatment of patients with schizophrenia with phenothiazine neuroleptics (chlorpromazine, triftazine)]. [Abstract of a Thesis for the Degree of Cand Sc (Med)]. Moscow: Moscow Helmholtz Research Institute for Eye Diseases; 1972. Russian. 3.Goldovskaia IL. [Psychotropic therapy and the visual system]. [Abstract of a Dissertation for the Degree of Dr Sc (Med)]. Moscow: Moscow Helmholtz Research Institute for Eye Diseases; 1989. Russian. 4.Murav'eva SV, Pronina MV, Moiseenko GA, Pnevskaya AN, Polyakov YuI, Kropotov YuD, et al. [A study on visual cognitive impairment in early schizophrenia and correcting it through the use of interactive virtual media]. Fiziol Cheloveka. 2017; 43 (6): 24–36. Russian. 5.Shoshina II, Shelepin YE. [The mechanisms of global and local analysis of visual information in schizophrenia]. St Petersburg: VVM; 2016. Russian. 6.Ferrari L, Huang SC, Magnani G, Ambrosi A, Comi G, Leocani L. Optical coherence tomography reveals retinal neuroaxonal thinning in frontotemporal dementia as in Alzheimer’s disease. J Alzheimer’s Dis. 2017;56(3):1101–7. 7.Akopyan VS, Boiko AN, Davydovskaya MV, Semenova NS, Filonenko IV, Fomin AV, Tsysar MA. [Retinal neuro-architecture in multiple sclerosis (MS): Optical coherence tomography diagnostic features]. Оftalmologiia. 2011;8(1):32–6. Russian. 8.Kovalenko AV, Boiko EV, Bisaga GN, Krasnoshchekova IeIe. [The role of optical coherence tomography in the diagnosis and treatment of demyelinating diseases]. Oftalmologicheskie vedomosti. 2010;3(1):4–10. Russian. 9.Gordon-Lipkin E, Chodkowski B, Reich DS, Smith SA, Pulicken M, Balcer LJ. Retinal nerve fiber layer is associated with brain atrophy in multiple sclerosis. Neurology. 2007 Oct 16;69(16):1603-9. 10.Ong YT, Hilal S, Venketasubramanian N, Niessen WJ, Vrooman H. Retinal neurodegeneration on optical coherence tomography and cerebral atrophy. Neurosci Lett. 2015 Jan 1;584:12-6. 11.Tiganov AS, Akopyan VS, Gavrilova SI, Semenova NS, Fedorova YaB, Gurova EV, Filonenko IV. [Thinning of the retinal ganglion cell layer in patients with Alzheimer's disease and mild cognitive decline: the diagnostic significance of spectral optical coherence tomography]. Vestnik OGU. 2013;153(4):263-6. Russian. 12.Lee JY, Ahn J, Kim TW, Jeon BS. Optical coherence tomography in Parkinson’s disease: is the retina a biomarker. J Parkinson’s Dis. 2014;4(2):197-204. 13.Moiseenko GA, Vakhrameeva OA, Lamminpiia AM, Pronin SV, Maltsev DS, Sukhinin MV, et al. [A study on the relationship between the size of foveola and visual perception characteristics]. Fiziol Cheloveka. 2018 Sep;44(5):22-9. Russian. 14.Mollon JD, Astell S, Reffin JP. A minimalist test of colour vision. Colour Vision Deficiencies. In: Drum B, Moreland JD, Serra A, editors. Colour Vision Deficiencies XI. Norwell, MA: Kluwer Academic Publishers; 1991. p. 59–67. 15.Tiganov AS, Snezhnevskii AV, Orlovskaia DD. [Manual of Psychiatry]. 2 volumes. Vol. 1. Moscow: Meditsina; 1999. Russian. 16.Pan J, Zhou Y, Xiang Y, Yu J. Retinal nerve fiber layer thickness changes in Schizophrenia. Psychiatry Res. 2018 Dec;270:786-791. 17.Ascaso FJ, Rodriguez-Jimenez R, Cabezon L, Lopez-Anton R, Santabarbara J, De La Camara C. Retinal nerve fiber layer and macular thickness in patients with schizophrenia: influence of recent illness episodes. Psychiatry Res. 2015 Sep 30;229(1-2):230-6. 18.Lee WW, Tajunisah I, Sharmilla K, Peyman M, Subrayan V. Retinal nerve fiber layer structure abnormalities in schizophrenia and its relationship to disease state: evidence from optical coherence tomography. Invest Ophthalmol Vis Sci. 2013 Nov 21;54(12):7785-92. 19.Yilmaz U, Kucuk E, Ulgen A, Ozkose A, Demircan S, Ulusoy DM. Retinal nerve fiber layer and macular thickness measurement in patients with schizophrenia. Eur J Ophthalmol. 2015;26:375–378. 20.Pantaleo Fornaro, Giovanni Calabria, Guido Corallo, Giovanni B Picotti. Pathogenesis of Degenerative Retinopathies Induced by Thioridazine and Other Antipsychotics: A Dopamine Hypothesis. Doc Ophthalmol. 2002 Jul;105(1):41-9. 21.Silverstein S, Paterno D, Cherneski L, Green S. Optical coherence tomography indices of structural retinal pathology in schizophrenia. Psychol Med. 2018 Sep;48(12):2023-2033. 22.Machekhin V.A. [Retinal tomography studies of the optic disc in health and glaucoma]. Moscow: Оftalmologiia; 2011. Russian.
The authors certify that they have no conflicts of interest in the subject matter or materials discussed in this manuscript.
|